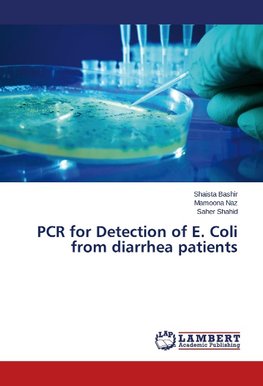
PCR for Detection of E. Coli from diarrhea patients

-
 Anglický jazyk
Anglický jazyk
PCR for Detection of E. Coli from diarrhea patients
Autor: Shaista Bashir
Bacterial diarrheal diseases represent one of the significant causes of human mortality and morbidity in developing countries that lack sufficient public health standards of sanitation. Escherichia coli is recognized to be the leading cause of diarrhea.... Viac o knihe
Na objednávku
36.99 €
bežná cena: 41.10 €
O knihe
Bacterial diarrheal diseases represent one of the significant causes of human mortality and morbidity in developing countries that lack sufficient public health standards of sanitation. Escherichia coli is recognized to be the leading cause of diarrhea. The aim of present study was to detect bfp gene in stool samples of diarrheal patients by polymerase chain reaction in order to facilitate its diagnosis. In this study E. coli was detected in 87.5 % samples of diarrheal patients by production of characteristic colonies on MacConkey agar plates. On TSI slants 62.5 % diarrheal samples were identified as E. coli. It was found that 3.5 mM concentration yielded best results and 0.5 µg template was used as the optimum concentration required for specific amplification of bfp gene. 20 % of pure diarrheal E. coli strains showed positive results for bfp gene of Enteropathogenic E. coli with PCR assay.
- Vydavateľstvo: LAP LAMBERT Academic Publishing
- Rok vydania: 2015
- Formát: Paperback
- Rozmer: 220 x 150 mm
- Jazyk: Anglický jazyk
- ISBN: 9783659706806












